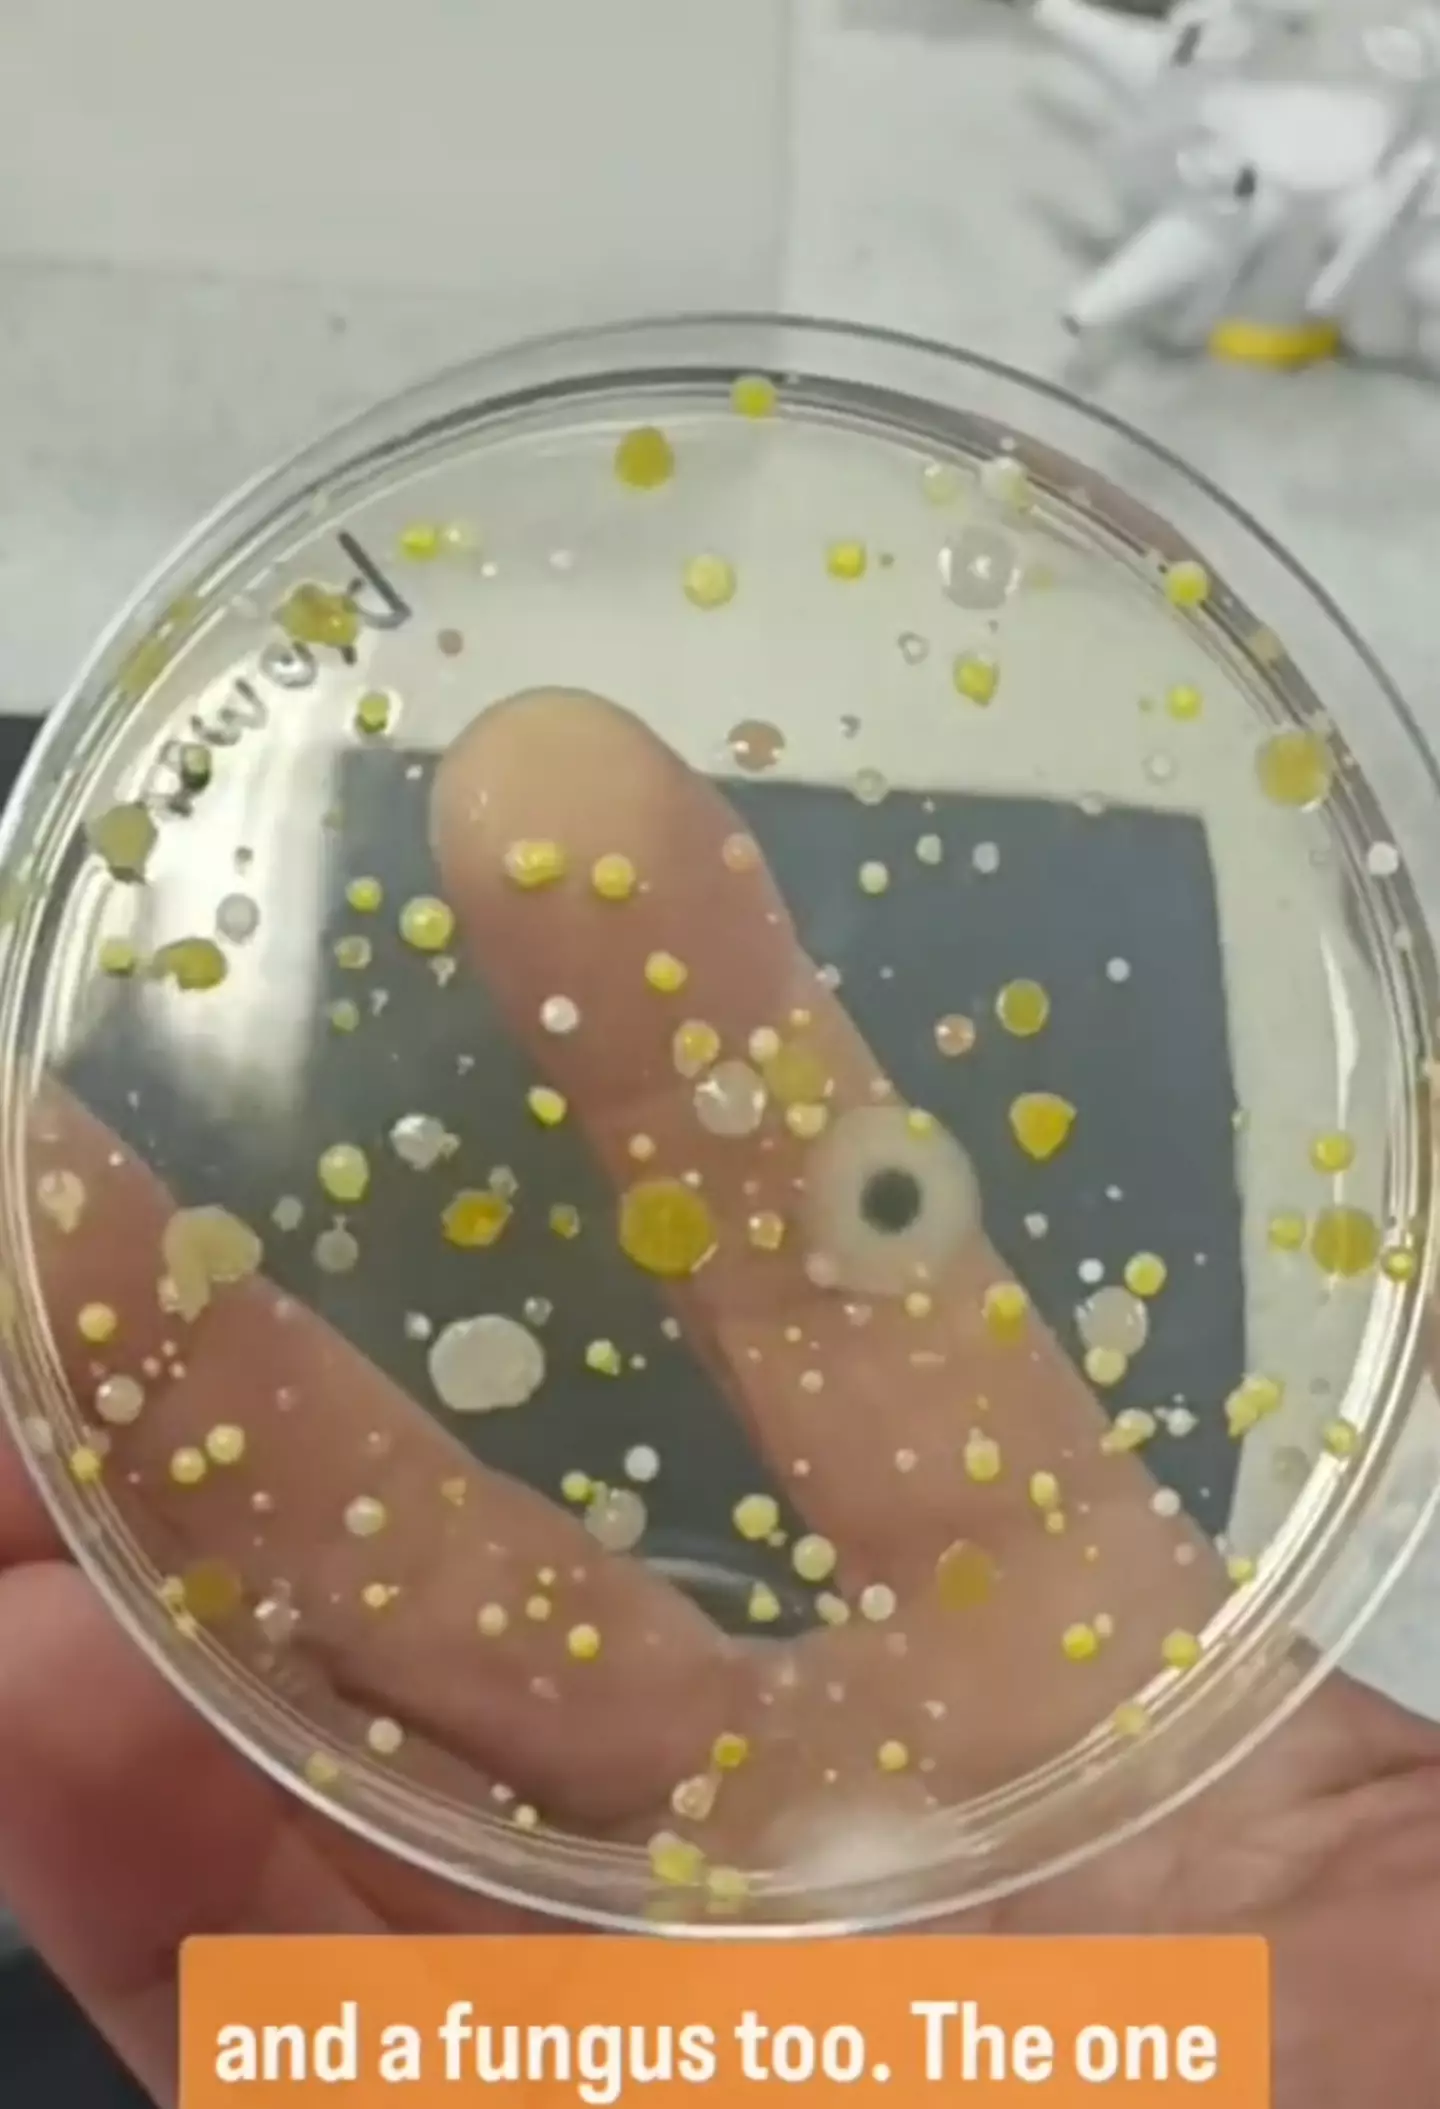

Public restrooms are a modern convenience, but they often leave us questioning just how clean they really are. While hand dryers are marketed as eco-friendly and cost-effective alternatives to paper towels, a recent experiment has exposed a grim truth: these devices might be far less hygienic than we thought. A viral TikTok experiment conducted by Ruth, known as Devon Science, has sparked widespread concern by revealing the bacteria lurking inside hand dryers and the potential risks they pose.
Ruth’s experiment was simple yet eye-opening: she placed a petri dish under a public hand dryer and let the machine do its job. After leaving the dish overnight, the results were nothing short of horrifying. The plate was covered in bacterial growth, including yellow spots, black smudges, and white patches. This experiment, which garnered over 4.7 million views, highlighted a critical issue—hand dryers are not just blowing air; they’re circulating bacteria onto freshly washed hands.
How Hand Dryers Spread Bacteria

So, what’s causing hand dryers to become bacterial blowers? The answer lies in their design and the environment they operate in. Public restrooms are filled with bacteria and other contaminants from high-touch surfaces like toilet handles, sinks, and floors. Every flush also releases a “toilet plume,” a cloud of microscopic droplets that can carry bacteria and viruses.
Hand dryers suck in the surrounding air, including all these contaminants, and blast it out at high speeds. Ruth’s follow-up experiment, where she swabbed the inside of a hand dryer and cultured it in a petri dish, confirmed that the bacteria wasn’t just airborne—it was living inside the machines. This means every time someone uses a hand dryer, they’re potentially spreading bacteria back onto their hands and into the air.
Are Hand Dryers Worse Than Other Drying Methods?
To provide context, Ruth also tested two alternative drying methods: air drying (waving hands) and using toilet paper. Here’s how they compared:
- Air Drying: Surprisingly, the petri dish exposed to air drying showed no bacterial growth, making it the most hygienic option—though it’s certainly the slowest.
- Toilet Paper: While not entirely germ-free, toilet paper produced far less bacterial growth than hand dryers. This suggests that even this improvised method is safer than the devices we’ve come to rely on.
The takeaway? Hand dryers might be convenient, but they’re far from the cleanest option for drying your hands.
The Hidden Danger Inside Hand Dryers
Ruth’s findings revealed a deeper issue: hand dryers don’t just spread bacteria—they harbor it. The moist, warm environment inside these machines creates a perfect breeding ground for microbes. Without regular cleaning and maintenance, these devices can turn into bacterial hubs.
While Ruth’s experiment didn’t identify the specific types of bacteria, their mere presence raises concerns. Public restrooms are used by countless people daily, so it’s not far-fetched to think these bacteria could include harmful pathogens. Whether it’s a harmless microbe or a dangerous germ, the thought of these organisms being blasted onto your hands is unsettling.
The Environmental Trade-Off: Are Hand Dryers Worth It?
Hand dryers became popular as an environmentally friendly alternative to paper towels, reducing waste and deforestation. However, their potential to spread bacteria raises questions about whether the trade-off is worth it. While paper towels contribute to landfill waste, they don’t pose the same hygiene risks as hand dryers. This dilemma forces us to weigh environmental benefits against public health concerns.
As facilities prioritize sustainability, it might be time to reconsider restroom hygiene policies. Should public restrooms offer both options, allowing users to choose based on their preferences? Striking a balance between eco-consciousness and cleanliness is a challenge worth addressing.
The Role of Restroom Air Quality
One major factor that contributes to the hygiene issue is restroom air quality. Public restrooms often lack proper ventilation, allowing bacteria and particles to linger in the air. Hand dryers exacerbate this problem by pulling in contaminated air and redistributing it at high speeds. This makes restroom air quality a critical aspect of overall hygiene, one that is often overlooked in discussions about public health.
How to Protect Yourself in Public Restrooms
If Ruth’s experiment has left you rethinking your hand-drying habits, here are some practical steps to stay safe in public restrooms:
- Air Dry When Possible
Let your hands dry naturally if you have the time. It’s the most hygienic option, even if it takes longer. - Use Toilet Paper
In the absence of paper towels, grab a piece of toilet paper to pat your hands dry. It’s not perfect but far better than risking exposure to hand dryer bacteria. - Carry Hand Sanitizer
Keep a small bottle of sanitizer with you. After washing and drying your hands, a quick application of sanitizer can provide an extra layer of protection. - Minimize Contact
Use tissues or your elbow to open restroom doors, avoiding direct contact with high-touch surfaces. - Advocate for Better Options
If you have a say in restroom policies—at work, school, or public venues—push for paper towel dispensers alongside hand dryers to give people a choice.
The Public Reaction to Ruth’s Findings
@devonscience Urghh, don't use a hand dryer😱🦠 —– Update: thank you for all your comments & suggestions. Totally blown away by how far this little video has reached 😮 I'm planning on doing some update videos on this experiment and will post on here, as well as on our FB & IG pages, which you are welcome to follow as well 😉 Thank you, Ruth (from Devon Science) #germs #publictoilet #bacteria #dirty #gross #justdont #scienceteacher #handwashchallenge #handdryer #science #scienceexperiments #microbiology #scienceproject #lesson #handdryer #handdryerbacteria ♬ original sound – Devon Science
Ruth’s experiment sparked a flood of reactions online. Many users expressed alarm and frustration, especially those working in places like hospitals where hygiene should be paramount. One commenter noted, “I work for the NHS, and they removed all the paper towels, leaving us with just hand dryers. It’s terrifying after seeing these results.”
Others vowed to stop using hand dryers altogether, choosing instead to air dry or carry their own solutions. The consensus was clear: while hand dryers are convenient, their hygiene risks make them less appealing in light of these findings.
Conclusion: Rethink Your Restroom Habits
Hand dryers may seem like an eco-friendly solution, but Ruth’s experiment exposes their significant hygiene drawbacks. These devices aren’t just blowing air—they’re blasting bacteria onto your freshly washed hands, raising serious concerns about their use in public spaces.
For now, it’s wise to opt for safer alternatives like air drying or using toilet paper whenever possible. As public awareness grows, we can hope for improved restroom designs that balance environmental sustainability with hygiene. Until then, the next time you step into a public restroom, think twice before pressing that hand dryer button—your health might depend on it.